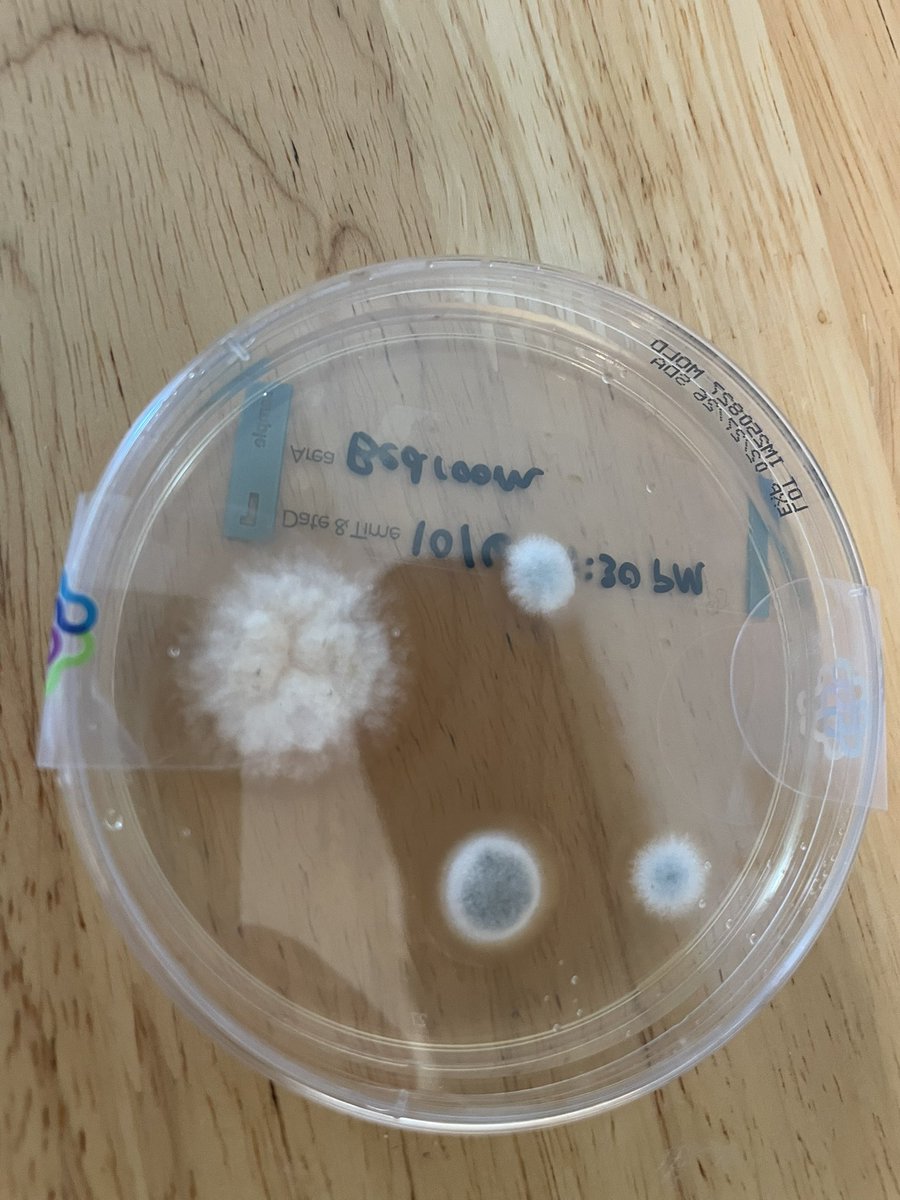
T3 nibbler tweet media

Sabitlenmiş Tweet
John Galt
806 posts

John Galt
@StudioMilitary
Designer @SportDrink + Military Studio. Contact via info (at) military (dot) studio.
Anti-Fluoride Katılım Mart 2024
90 Takip Edilen7.5K Takipçiler
John Galt retweetledi

@Anarseldain Because Asians primarily have entirely different breed of cat. They usually have British Shorthairs (and munchkin versions of those) which are the perfect cat. They're also way smarter and have much more personality
English

I’m not sure exactly what it is, if it has to do primarily with selective breeding, but the Japanese have insane cat tech that we haven’t yet unlocked. Far more advanced. Japan is at least 200 years ahead of us in this respect.
F美と飼い主@FM_calico
おててがかくれんぼしてるんだねぇ
English

@nateberkopec Aside from the blue overlay, this is just how it looks in certain lighting. The PFN640+ is a great thermal
English

@StudioMilitary did you post-process this or is that really how it looks in-camera? incredible aesthetics
English
John Galt retweetledi

Listen to my song, okay?
And if you like it, there's more in my media tab...
John Galt@StudioMilitary
A Song for Walter, about an era the world misses Made with a drum machine and guitar
English
John Galt retweetledi
John Galt retweetledi

@cynomaxxx There's little guys in my wall that I have to kill so I can live
English


Websites should be this again. Waiting for the first company to do authentically do it. Everything looks like a venture capitalist yoga retreat website atm
Web Design Museum@WebDesignMuseum
Sony website in 2002 #WebDesignHistory
English

After two years building the @NousResearch brand and comms, myself and @rivatez have resigned. More on that later.
We are launching a creative agency to take on new projects.
We care about the principles of self-sovereignty and censorship resistance, and will choose projects based on shared philosophy.
Reach out to info@militarystudio.com
English

@zeroXmusashi @NousResearch @rivatez Anything you saw design-wise at Nous was likely me, merch included. If it was good, I did it
English

@StudioMilitary @NousResearch @rivatez oh nice -- if you guys are the ones responsible for all of the sweet merch and associated graphic design, i might be interested in working with your agency, as i am a big fan
maybe i'll shoot you an email
English

@StudioMilitary @NousResearch @rivatez All the best with your next endeavour! Since you’re into design this book might interest you btw, I haven’t read it so can’t vouch for the content


English